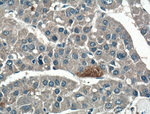
PLEKHM1 Antibody in Immunohistochemistry (Paraffin) (IHC (P))

Search
Proteintech
PLEKHM1 Polyclonal Antibody
{{$productOrderCtrl.translations['antibody.pdp.commerceCard.promotion.promotions']}}
{{$productOrderCtrl.translations['antibody.pdp.commerceCard.promotion.viewpromo']}}
{{$productOrderCtrl.translations['antibody.pdp.commerceCard.promotion.promocode']}}: {{promo.promoCode}} {{promo.promoTitle}} {{promo.promoDescription}}. {{$productOrderCtrl.translations['antibody.pdp.commerceCard.promotion.learnmore']}}
产品信息
16202-1-AP
种属反应
宿主/亚型
分类
类型
抗原
偶联物
形式
浓度
规格
纯化类型
保存液
内含物
保存条件
运输条件
产品详细信息
Immunogen sequence: EALKCFRIR NNEKMLSDSH GVETIRDILP DTSLGGPSFF KIITAKAVLK LQAGNAEEAA LWRDLVRKVL ASYLETAEEA VTLGGSLDEN CQEVLKFATR ENGFLLQYLV AIPMEKGLDS QGCFCAGCSR QIGFSFVRPK LCAFSGLYYC DICHQDDASV IPARIIHNWD LTKRPICRQA LKFLTQIRAQ PLINLQMVNA SLYEHVERMH LIGRRREQLK LLGDYLGLCR SGALKELSKR LNHRNYLLES PHRFSVADLQ QIADGVYEGF LKALIEFASQ HVYHCDLCTQ RGFICQICQH HDIIFPFEFD TTVRCAECKT VFHQSCQAVV KKGCPRCARR RKYQEQNIFA (708-1056 aa encoded by BC064361)
靶标信息
PLEKHM1 is a member of the M family of Pleckstrin homolog domain-containing proteins, a group of proteins containing a RUN domain, two pleckstrin homology domains, and a cysteine-rich domain. It was identified through segregation analysis as a cause of osteopetrosis in humans. PLEKHM1 co-localizes with Rab7 to late endosomal/lysosomal vesicles in HEK293 and osteoclast-like cells, with this co-localization dependent on the prenylation of Rab7. Monocytes from a patient homozygous for a mutated form of PLEKHM1differentiated into osteoclasts normally, but failed to form ruffled borders and showed little evidence of bone resorption when cultured on dentine discs. Another mutation of PLEKHM1 impaired vesicular acidification and increased TRACP secretion in osteoclasts, suggesting that PLEKHM1 has critical roles in endosomal maturation and may be important in osteoclast-osteoblast cross-talk.
仅用于科研。不用于诊断过程。未经明确授权不得转售。
生物信息学
蛋白别名: 162 kDa adapter protein; AP162; PH domain-containing family M member 1; pleckstrin homology domain containing, family M (with RUN domain) member 1; Pleckstrin homology domain-containing family M member 1; unnamed protein product
基因别名: AP162; B2; BC038943; D330036J23Rik; KIAA0356; OPTA3; OPTB6; PLEKHM1
UniProt ID: (Human) Q9Y4G2, (Mouse) Q7TSI1, (Rat) Q5PQS0
Entrez Gene ID: (Human) 9842, (Mouse) 353047, (Rat) 303584